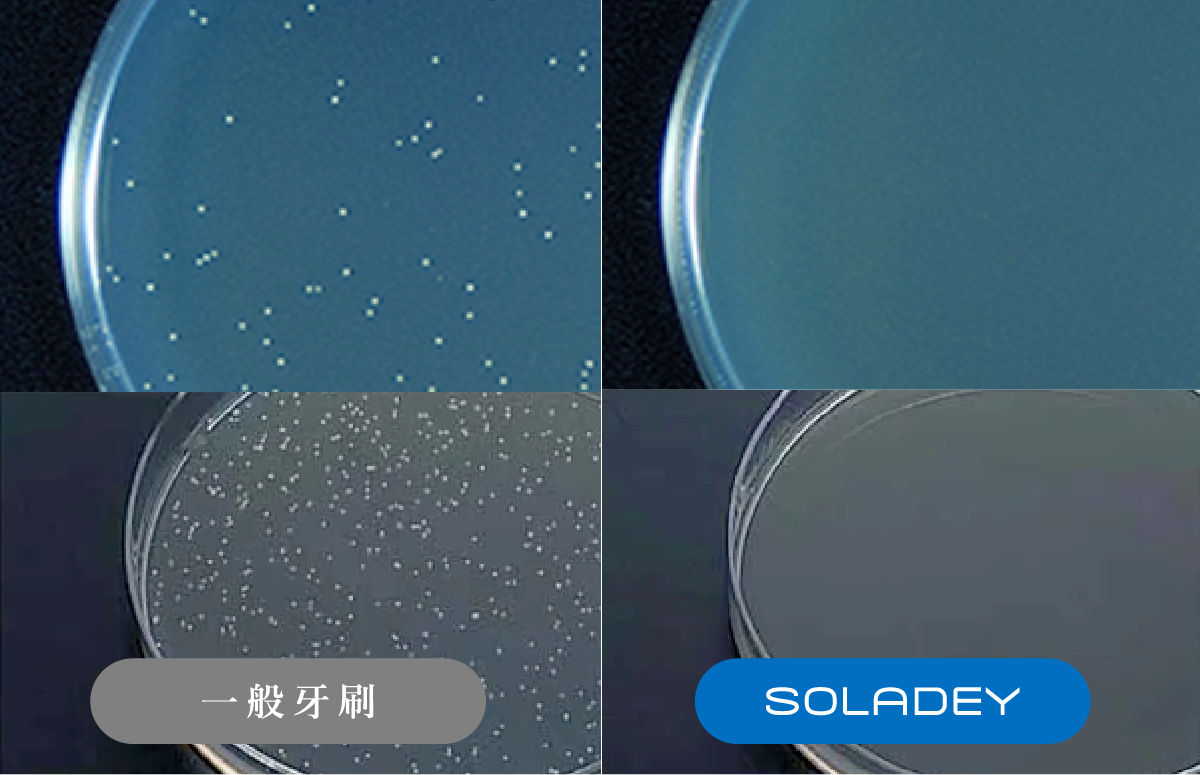

{{ 'fb_in_app_browser_popup.desc' | translate }} {{ 'fb_in_app_browser_popup.copy_link' | translate }}
{{ 'in_app_browser_popup.desc' | translate }}
{{ childProduct.title_translations | translateModel }}
{{ getChildVariationShorthand(childProduct.child_variation) }}
{{ getSelectedItemDetail(selectedChildProduct, item).childProductName }} x {{ selectedChildProduct.quantity || 1 }}
{{ getSelectedItemDetail(selectedChildProduct, item).childVariationName }}
✨日本累計銷量超過 1600 萬隻牙刷✨
專利技術|有效抑制口腔細菌、預防牙菌斑產生
極致潔淨|客制替換刷頭,有效清潔牙面齒垢
貼心設計|刷毛貼合齒溝,輕鬆清潔齒縫死角
圓潤外觀|貼合手掌弧度,更好施力輕鬆刷牙
無須充電|有光和水即可使用,更加環保節能
收納方便|極好拆卸,收在行李箱也不佔空間
世界認證|15國獨家專利光觸媒牙刷領導品牌
商品存貨不足,未能加入購物車
您所填寫的商品數量超過庫存
{{'products.quick_cart.out_of_number_hint'| translate}}
{{'product.preorder_limit.hint'| translate}}
每筆訂單限購 -1 件
{{'products.quick_cart.quantity_of_stock_hint'| translate : {message: quantityOfStock} }}

大家好~我們是 SOLADEY 齒科護理團隊,從 1981 年開始透過持續不斷地改進產品,四十年來與牙科和理工化學專家合作,藉由無數次的研究及測試,開發出了 SOLADEY 系列的光觸媒負離子牙刷來改善人們的生活,從日本當地推廣並成為累計銷量超過 1600 萬隻牙刷的老字號品牌。



✧





除了,可以吸收室內光源即可產生負電子外,太陽能電池板相較電動牙刷來說,也不需要更換電池或者另外充電,環保節能又方便。

一般牙刷和光觸媒負離子牙刷浸泡在細菌培養液中三分鐘後,放置在培養基上培養約 48 小時後,可以清楚的看到光觸媒負離子牙刷有效地抑制了细菌生長。















SOLADEY® 系列是與 12 所大學 40 年共同研究的成果,至今擁有包含臺灣在內的 15 國獨家專利認證、多項臨床研究證實
全系列累計銷售超過 1620 萬支,被眾多為選牙刷而煩惱的人所使用。
【SOLADEY 5|光觸媒負離子牙刷】在日本及各國都獲得口腔專家的推薦和肯定,團隊這次也請到高竿牙藝牙醫診所的幾位牙醫師實際試用來測試產品性能。